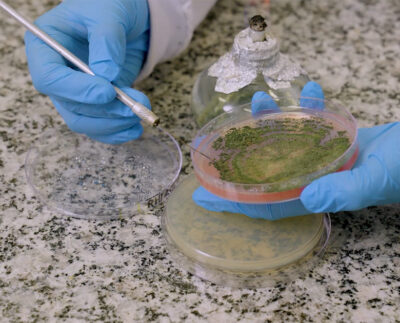

- 16 de setembro de 2024
Biológicos atuam de maneira eficaz no controle de Doenças de Final de Ciclo
“O controle das doenças de Final de Ciclo (DFC), que são um grupo de doenças fúngicas que afetam diversas…
- 2 de agosto de 2024
Biológicos ganham espaço no Congresso da Andav
Novas tecnologias, entre elas fixadores de nitrogênio concentrados, serão apresentadas no maior evento voltado para o setor de insumos…
- 8 de julho de 2024
Inteligência Artificial impulsiona biotecnologia e sustentabilidade no agro
Startup utiliza bioinformática e inteligência artificial na seleção genética de microorganismos com características desejadas para o desenvolvimento de novos produtos biológicos de alta…
- 1 de julho de 2024
Controle de doenças: Bioinsumos são grandes aliados no combate de doenças sazonais nas lavouras
Causadas por fungos, essas enfermidades são responsáveis por grandes perdas nas lavouras brasileiras todos os anos; Biocontrole é chave para redução de danos Com o inverno…
- 10 de junho de 2024
Tecnologia inovadora para acessibilizar o controle biológico
Com a criação em larga escala “on farm” do inseto crisopídeo, um inimigo natural eficaz no combate de diferentes…
- 5 de junho de 2024
Insumos biológicos protegem lavouras de trigo em tempos de instabilidade climática
O Brasil, que bateu recordes de produtividade de trigo nos últimos anos, deve ter queda na safra 2023/2024, colhendo cerca de 8,09…
- 20 de maio de 2024
BASF lança linha de bioadjuvantes que aumenta a eficiência de defensivos biológicos
Bioadjuvantes auxiliam no combate de pragas e patógenos no campo potencializando o efeito dos agentes de controle Biológicos A…
- 19 de abril de 2024
Uso de bioinsumos cresce e já alcança 31% da área cultivada no país, diz estudo
Levantamento indica que 60% das propriedades rurais no Brasil já utilizam algum biológico Os bioinsumos não são mais novidade…
- 17 de abril de 2024
A revolução dos biológicos e os benefícios à agricultura, às pessoas e ao planeta
A demanda por insumos biológicos na agricultura vem ganhando força no Brasil e já reflete em uma tendência de…
- 12 de abril de 2024
Com estratégia robusta em biológicos, ICL dá mais um passo em inovaçãoe firma parceria de desenvolvimento com a startup Ideelab Biotecnologia
Um mês após aquisição da Nitro 1000, companhia anuncia o desenvolvimento de novos produtos biológicos em parceria com a…